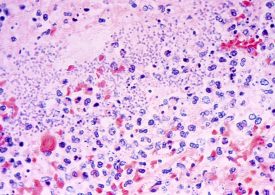
A Person in Arizona Has Died From Plague. Who’s Most at Risk of Contracting It, and How Can You Protect Yourself?

A person in Arizona has died from pneumonic plague, local health officials said on Friday. Pneumonic plague, which occurs when the bacterium Yersinia pestis gets…
Day: July 11, 2025
Man drives nearly 200 miles before realising he left his WIFE at petrol station during holiday trip
Getty A MAN on holiday drove almost 200 miles before remembering he had left his wife at a petrol station. The 62-year-old, from Paris, was…
Russia accuses Trump of ‘sponsoring terrorist scum’ after US agrees to send weapons and key Patriots to Ukraine via NATO
RUSSIA has lashed out at Donald Trump after the US president agreed to send vital Patriot air defence systems to help Ukraine. Trump told NBC…
Chilling new Russian tactic to maim and kill civilians in Ukraine revealed as Putin cranks up attacks
RUSSIA is firing drones packed with shrapnel at Ukraine to kill and maim civilians — and wants to launch 1,000 every day. President Vladimir Putin…
Inside secret Ibiza shanty town riddled with snakes where superclub workers live in squalor with no water or electricity
AS dawn breaks and the thump of Ibiza’s wild nightlife begins to subside, the ramshackle shanty town is starting to awake. Folk emerge from mosquito-…
Putin’s elite commander of bloodthirsty brigade accused of horror war crimes and massacres wiped out in Ukraine strike
VLADIMIR Putin’s brutal war machine was dealt another blow today as Moscow confirmed the death of another top Russian military chief. Russian authorities have confirmed…
Without Birthright Citizenship, Americanness Hangs by a Thread
President Donald Trump is attempting to rewrite the Constitution without amending it, one executive order at a time. One of his biggest targets: the birthright…
Superman Is Punk Rock, After All
In the battle for supreme superhero coolness, Batman has been the unofficial champ for nearly 40 years. In 1988, Alan Moore and Brian Bolland rescued…
Air India pilots made fatal error after takeoff causing jet to plummet to ground killing 260, crash investigators claim
PILOT error is suspected in the Air India crash which killed 260 people including 52 Britons, The Sun can reveal. Analysis of the Boeing 787…
What Superman’s End-Credits Scenes Mean—For the DC Universe and the Movies
Warning: This post contains spoilers for the endings of Superman, Sinners, and 28 Years Later. Let’s get this out of the way. Does Superman have…